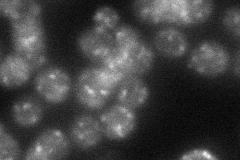
YGL167C
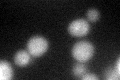
YGL167C
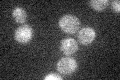
YGL167C

View description
High affinity Ca2+/Mn2+ P-type ATPase required for Ca2+ and Mn2+ transport into Golgi; involved in Ca2+ dependent protein sorting and processing; mutations in human homolog ATP2C1 cause acantholytic skin condition Hailey-Hailey disease
Localization:
Intensity:
Fold change:
Significance:
-
C’ GFP library in SD

ER25.32 -
N' NOP1pr-GFP in SD

punctate128.592 -
N' TEF2pr-mCherry in SD

punctate151.556 -
N' NATIVEpr-GFP in SD
punctate34.2125 -
N' TEF2pr-VC and Cyto-VN in SD

punctate37.5309 -
C’ GFP library in SD+DTT
ER22.790.89No -
C’ GFP library in SD+H2O2

ER21.720.85No -
C’ GFP library in Starvation Media
ER19.480.76Yes -
C’ GFP library on the background of Pup2-DaMP

ER -
C’ GFP library on the background of CCT mutant

ER18.96670.748837No
